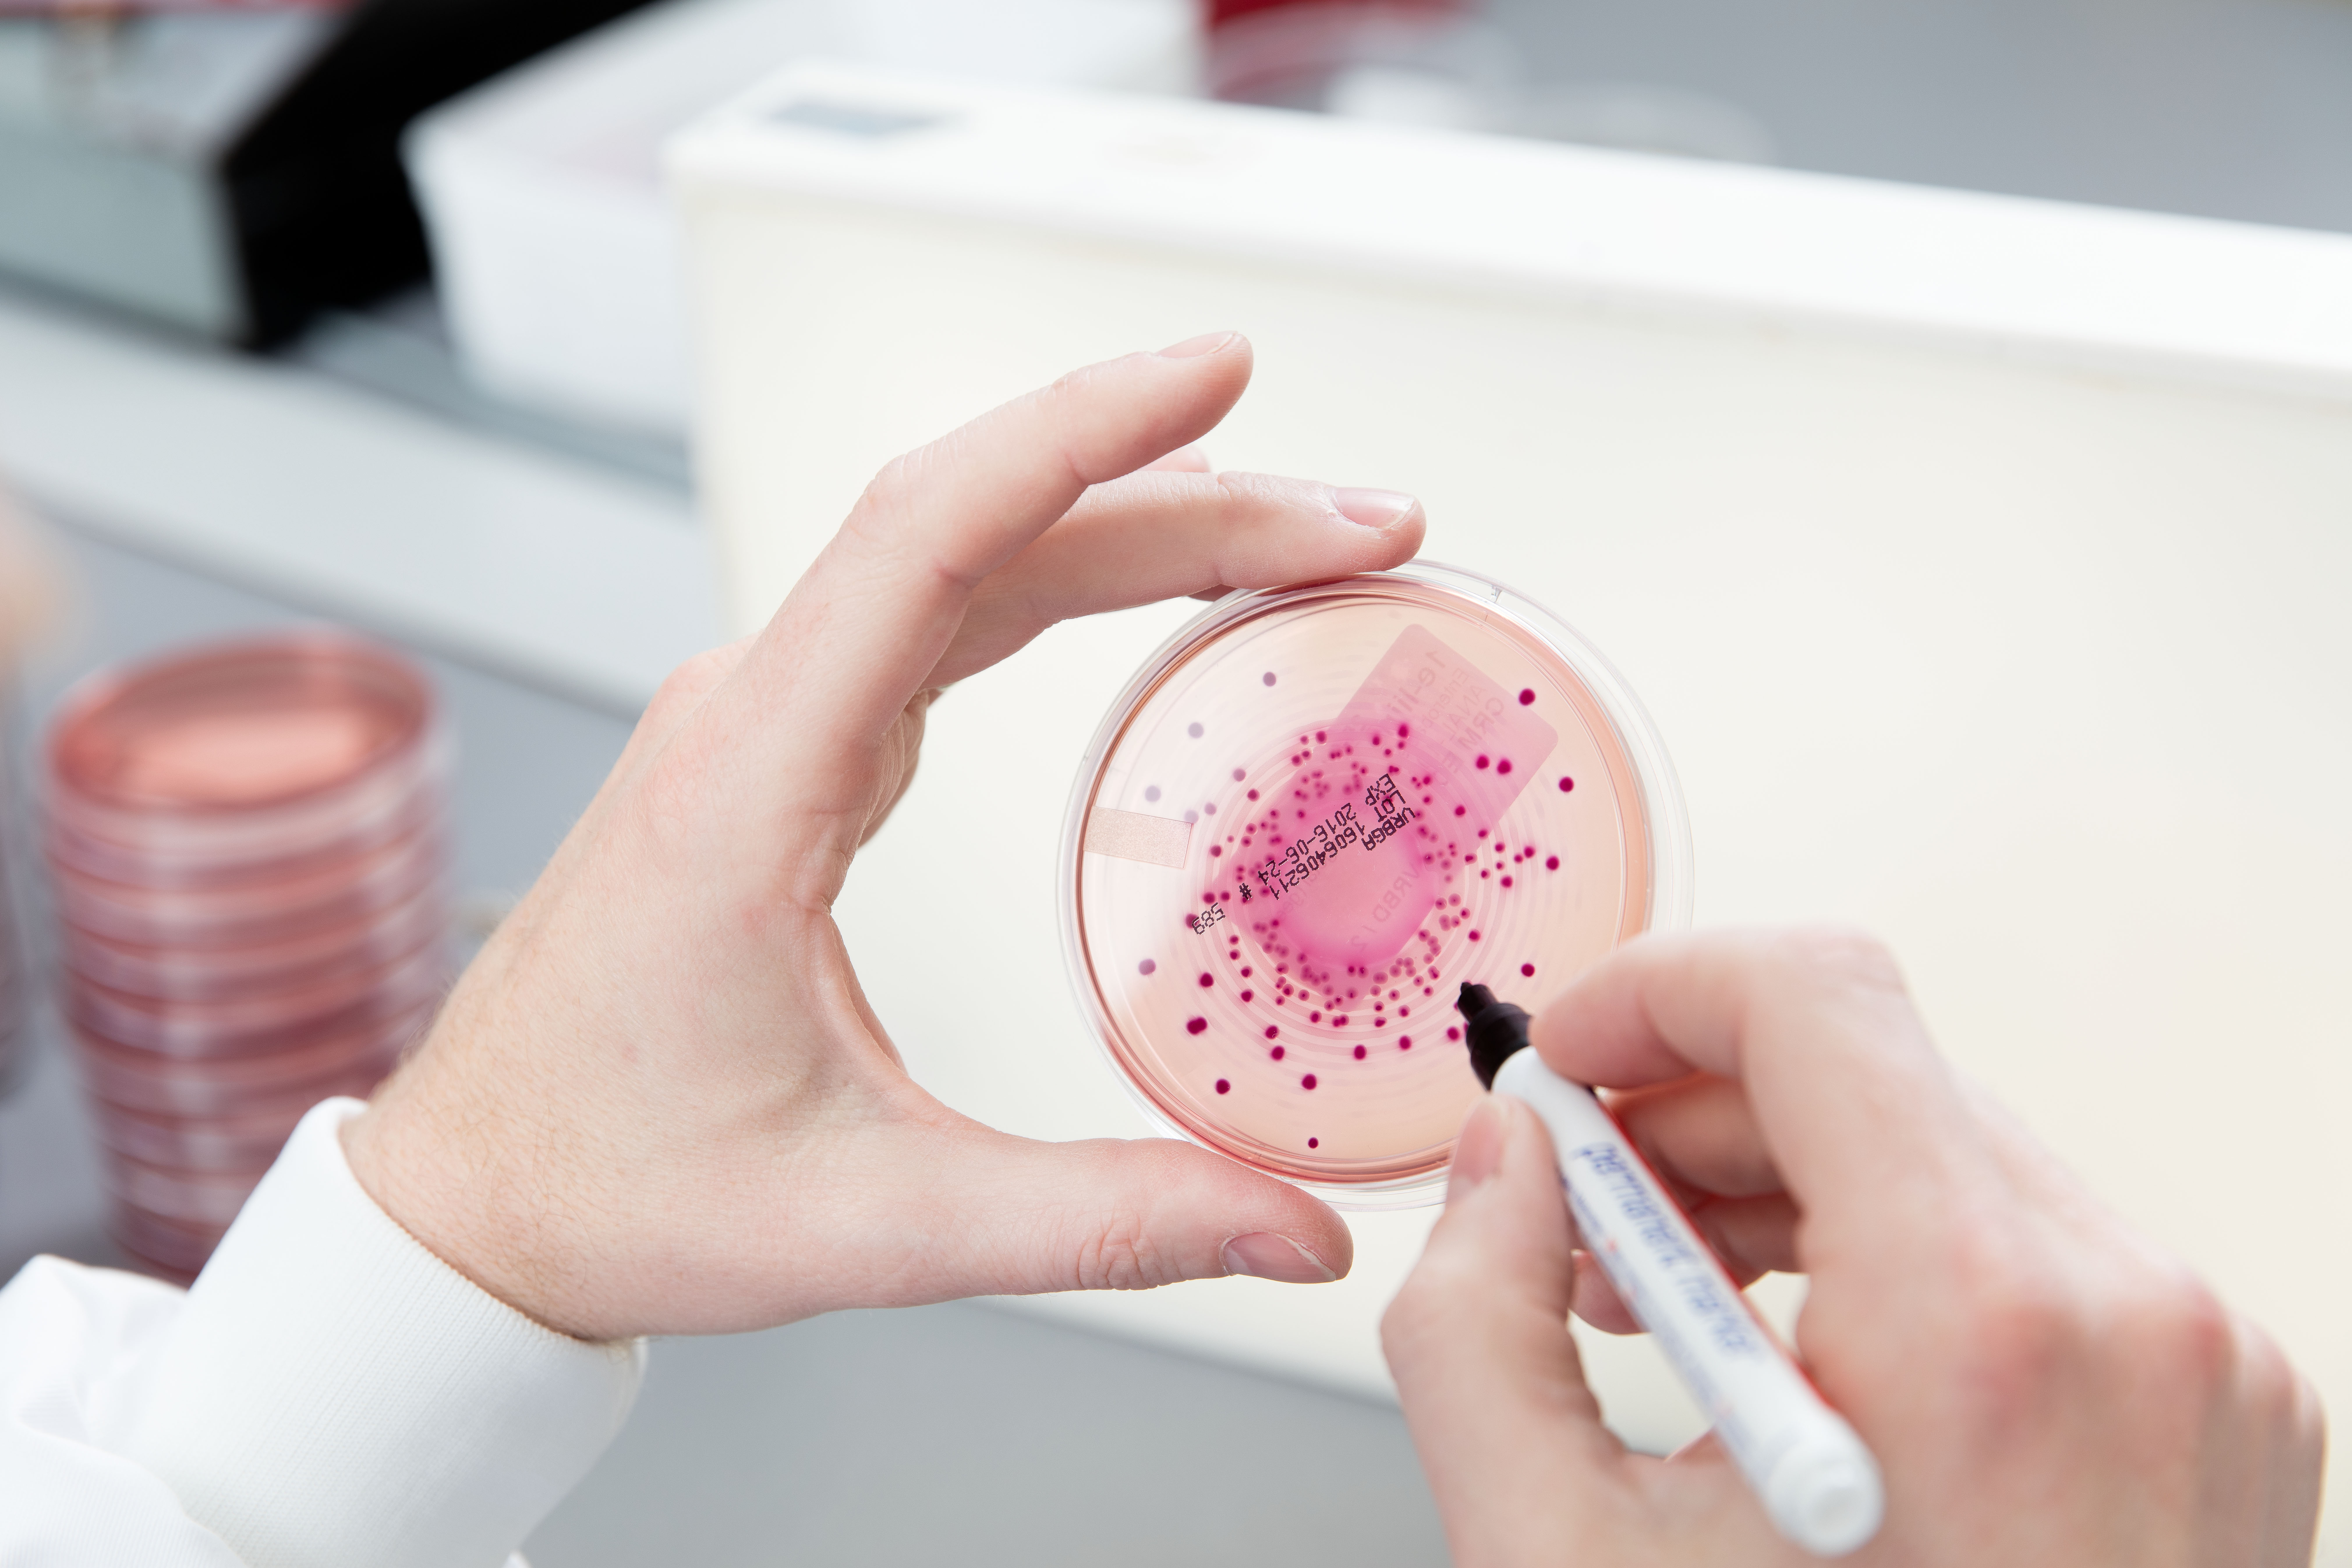

Café René: Geijkte drama's bij een zuivelbedrijf
"Je ziet toch dat de weegschaal het doet?" De technische dienst toonde mij de originele verpakking van hun 'geijkte' thermometer met een vergeeld, vijf jaar oud controlebriefje. "Kijk zelf maar, de thermometer in de pasteur en die op het computerscherm zijn hetzelfde." Brr. Dit artikel is verschenen in VMT 11.